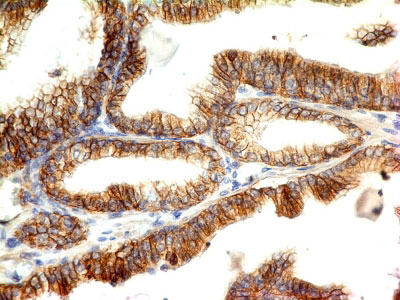

> Antigen, Antibodies, ELISA, Western Blot > Primary Antibody > Monoclonal Antibodies > E-Cadherin / CD324 (Intercellular Junction Marker) Antibody - Without BSA and AzideBrand |
Leading Biology | Catalog Number |
AMM01659G |
Product Type |
Monoclonal Antibodies | Field of Research |
|
Product Overview |
We constantly strive to ensure we provide our customers with the best antibodies. As a result of this work we offer this antibody in purified format.
We are in the process of updating our datasheets. If you have any questions regarding this update, please feel free to contact our technical support team.
This product is a high quality E-Cadherin / CD324 (Intercellular Junction Marker) Antibody - Without BSA and Azide.
|
||
Molecular Weight |
120-80kDa (Mature); 135kDa (Precursor)
|
||
Cellular Localization |
Antigen Cellular Localization:
Cell junction. Cell membrane; Single-pass type I membrane protein. Endosome. Golgi apparatus, trans-Golgi network. Note=Colocalizes with DLGAP5 at sites of cell-cell contact in intestinal epithelial cells. Anchored to actin microfilaments through association with alpha-, beta- and gamma- catenin. Sequential proteolysis induced by apoptosis or calcium influx, results in translocation from sites of cell-cell contact to the cytoplasm. Colocalizes with RAB11A endosomes during its transport from the Golgi apparatus to the plasma membrane
|
||
Host |
Mouse
|
||
Species Reactivity |
Human
|
||
Clone |
CDH1/1121
|
||
Isotype |
Mouse / IgG1, kappa
|
||
Symbol |
CDHE, UVO
|
||
GeneID |
|||
UniProt ID |
|||
Function |
Cadherins are calcium-dependent cell adhesion proteins. They preferentially interact with themselves in a homophilic manner in connecting cells; cadherins may thus contribute to the sorting of heterogeneous cell types. CDH1 is involved in mechanisms regulating cell-cell adhesions, mobility and proliferation of epithelial cells. Has a potent invasive suppressor role. It is a ligand for integrin alpha-E/beta-7.
|
||
Summary |
Recognizes a protein of 120-80kDa, identified as E-cadherin. Cadherins comprise a family of Ca2+-dependent adhesion molecules that function to mediate cell-cell binding critical to the maintenance of tissue structure and morphogenesis. The classical cadherins, E-, N- and P-cadherin, consist of large extracellular domains characterized by a series of five homologous NH2 terminal repeats. The relatively short intracellular domains interact with a variety of cytoplasmic proteins, such as ? ?-catenin, to regulate cadherin function. E-cadherin plays an important role in epithelial cell adhesion. A decreased expression of E-cadherin is associated with metastatic potential and poor prognosis in breast cancer, prostate and esophageal cancer. In combination with p120 Catenin, it is useful for the differentiation between ductal (E-cadherin +) and lobular (E-cadherin -) breast carcinomas. It may also help in diagnosis of mesothelioma.
|
||
Form |
Liquid |
||
Storage & Stability |
Store at +4°C short term. For long-term storage, aliquot and store at -20°C or below. Stable for 12 months at -20°C. Avoid repeated freeze-thaw cycles.
|
||
Applications |
WB, IHC, IF, FC
|
||
Images |
Formalin-fixed, paraffin-embedded human Colon Carcinoma stained with E-Cadherin Monoclonal Antibody (CDH1/1121). 
Formalin-fixed, paraffin-embedded human Skin stained with E-Cadherin Monoclonal Antibody (CDH1/1121). 
Western Blot Analysis A) Recombinant Protein (B) human Stomach Lysate using E-Cadherin Monoclonal Antibody (CDH1/1121). |
||
Specification |
|||
Quantity |
|
||
| Select | Brand | Catalog No. | Product Name | Pack Size | Type | Field of Research | Specification | Quantity | Price(USD) | |
| 1 | Leading Biology | APG02467G | CCK4 / PTK7 Antibody (clone 4F9) | 50 μl | Monoclonal Antibodies |
|
$495.00 | Add Ask | ||
| 2 | Leading Biology | AMM04683G | GALT Antibody (clone 4C11) | 50 μg | Monoclonal Antibodies |
|
$545.00 | Add Ask | ||
| 3 | Leading Biology | AMM01402G | Vimentin (Mesenchymal Cell Marker) Antibody - With BSA and Azide | 50 ug | Monoclonal Antibodies |
|
$395.00 | Add Ask | ||
| 4 | Leading Biology | APR08280G | LTA4H / LTA4 Antibody (clone 9G8) | 50 μl | Monoclonal Antibodies |
|
$495.00 | Add Ask | ||
| 5 | Leading Biology | AMM00172G | CD1a / HTA1 (Mature Langerhans Cells Marker) Antibody - With BSA and Azide | 50 ug | Monoclonal Antibodies |
|
$395.00 | Add Ask | ||
| 6 | Leading Biology | AMM05750G | CEBPA Antibody | 100 μl | Monoclonal Antibodies |
|
$545.00 | Add Ask |
 Leading Biology Inc.
2600 Hilltop DR, Building G, B Suite C138
Richmond, CA, 94806
Tel: 1-661-524(LBI)-0262
Email: info@leadingbiology.com
Leading Biology Inc.
2600 Hilltop DR, Building G, B Suite C138
Richmond, CA, 94806
Tel: 1-661-524(LBI)-0262
Email: info@leadingbiology.com
Complete this form and click send to ask us a question, request a quote or simply say hello.

You have 0 item in your cart

You have 0 item in your inquiry list
